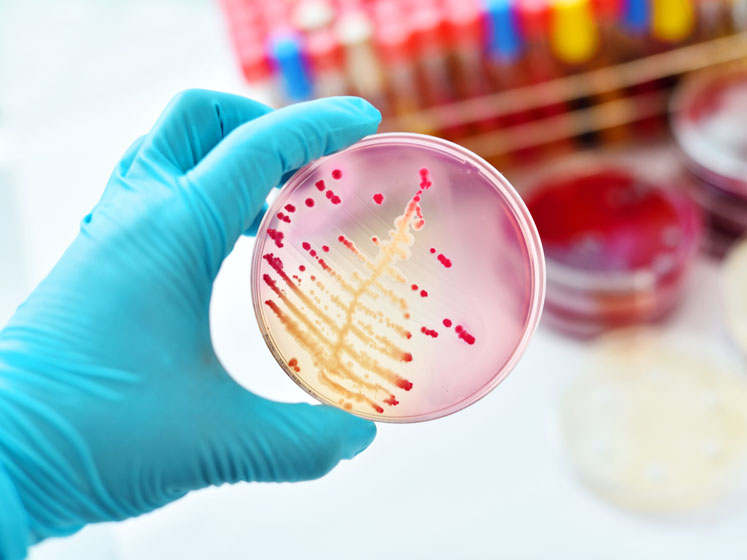

To create safe and effective drug products and medical devices, manufacturers spend a significant amount of time and money to research, develop and scale-up efficient manufacturing processes.
With so much focus on process optimisation, it can be easy to lose sight of other equally important tasks, including microbial control.
Microbes can be brought into manufacturing suites with raw materials or by operators. Some of these micro-organisms are harmless to humans, but others are not and can lead to serious illness or even death if present as contaminants in final drug products and medical devices.
The effectiveness of disinfectant regimes employed in these cleaning procedures must be demonstrated to destroy any common organisms recovered in the relevant classified areas through appropriate microbial identification in trending efforts.
It is incumbent on pharmaceutical product manufacturers to ensure microbial control in production areas through environmental monitoring, microbial identification and trending, and the use of proven and continually updated cleaning/disinfectant protocols.
These steps must be taken to ensure compliance with applicable regulatory requirements that are intended to ensure the quality of drugs, medical devices and, thus, patient safety.1–8
Identification and trending of common microbes
Detecting the presence of microbes is not sufficient. Identification is essential to understand the risk that each one poses. Tracking and trending growth patterns is equally important because it facilitates the discovery of conditions that may result in out-of-specification counts or conditions.
Understanding the factors that impact the maintenance and control of microbial contamination, therefore, enables more effective production planning and risk management.
Identification
Microbial identification can be achieved using a variety of methods that provide differing levels of information, including Gram staining, ribosomal protein analysis via matrix assisted laser desorption-time of flight (MALDI-TOF) spectroscopy and genetic sequencing (genotypic method) via DNA amplification and the use of polymerase chain reaction technology.
Each has limitations and the best approach to microbial identification is to employ a combination of these three methods.
Once the organisms that are commonly present in classified manufacturing areas have been identified, it should be determined whether their presence is expected or not.
This requires understanding the ecology of the organisms and the specific sites in the manufacturing environment from which samples were collected.
The occurrence of organisms in areas that cannot be readily explained by their ecology — particularly within the context of a pharmaceutical manufacturing facility — must be investigated to identify the reason for their presence.
As importantly, the identification of pathogenic species enables the development of an appropriate response. The level of growth for each of the common organisms identified should also be trended; plus, they should be incorporated into media growth promotion studies to ensure truly robust media fill and environmental monitoring programmes.
Trending
The collection of robust trending data for the presence of microbes identified as common in the manufacturing environment can reveal unexpected growth patterns. Trending is essential to avoid single sample results that only give a snapshot of the microbes present at a specific time.
The causes of increasing growth can then be determined and addressed before growth levels exceed specifications. In addition, the use of robust trending data in microbial control strategies is preferred by the US FDA.9
Trending results are typically evaluated at the genus level. Therefore, if most of the microbes identified in a manufacturing area are identified as species of Micrococcus or Staphylococcus, both of which are derived from human sources, and found to be trending in a similar manner, then one representative organism can be used for disinfectant prequalification (see below).
If spore formers are also found to be trending, such as those of the Bacillus genus, then one of these organisms should also be used for further testing because they are more resilient than other organisms and able to survive for longer periods of time … even in harsh environments.
Disinfectant testing and qualification
Many of the organisms detected in a manufacturing facility will likely be those identified in regulatory guidance documents.1–8 There will typically be some, however, that are not included on these lists.
Both environmental isolates of these organisms and recommended organisms that are representative of what has been observed in the manufacturing area should be grown and used in disinfectant qualification studies.
Failure to demonstrate that organisms commonly found in a facility can be recovered has resulted in the issuance of FDA warning letters.10
For growth promotion testing of the isolates, it is essential that the correct media is properly prepared and stored. Because the medium and growth conditions can affect the growth of micro-organisms, each organism should be grown on different types of media to ensure that they can be recovered.
Disinfectant efficacy testing should be performed using organisms commonly found in the manufacturing area as frequently as necessary to address any questions raised by trending data or when it is necessary to introduce new disinfectants.
The choice of disinfectants is determined by their efficacy against the range of organisms that must be eliminated. Exposure (wet contact) times are typically recommended by the disinfectant suppliers.
Tests may include in-suspension studies to screen new disinfectants for effectiveness, carrier surface studies — also known as coupon testing or surface challenge studies — to determine the effectiveness of disinfectants to reduce microbial levels on the specific surfaces found in a given manufacturing area, and in-situ field studies (statistical comparison tests) for the evaluation of disinfectants in the manufacturing area.

It is important to test the disinfectants on all the different surfaces that could be exposed, because certain disinfectants may perform better on smooth versus rough or porous versus non-porous substrates.
Use of disinfectants close to or slightly beyond the expiry date is recommended. Surface studies should mimic the actual cleaning regimen that will be applied by operators daily and be as simple as possible.
A comprehensive cleaning regimen should be established based on the results of the prequalification studies. The potential impacts of the specific disinfectants on the people using them and the environment should be taken into consideration, including the generation of residues that could potentially be a source of endotoxin contamination.
A protocol may require the use of more than one disinfectant/sporicide in sequence or rotation of different disinfectants/sporicides to ensure effective ongoing decontamination.
In general, it is recommended to rotate a disinfectant with a sporicide rather than another disinfectant. Once disinfectant prequalification testing is complete and procedures are established or updated, a disinfectant efficacy testing (DET) package should be organised to facilitate future audits.
Ongoing process
Continuous environmental monitoring, microbial identification and disinfectant qualification ensures that selected disinfectant reagents continue to be effective against organisms present in the manufacturing area … even if new microbes appear or the growth patterns of existing organisms change.
New prequalification studies will also be necessary if any disinfectants used in current cleaning protocols are expected to be discontinued.
For instance, at least every 15 years in the US, the Environmental Protection Agency reviews all registered antimicrobial compounds, including active disinfectant ingredients, as required by the Federal Insecticide, Fungicide and Rodenticide Act. Different ingredients are reviewed each year and manufacturers must provide data to support the continued use of their products.11
One recent Data-Call-In (DCI) led to the phasing out of paratertiary amylphenol (PTAP) and the subsequent discontinuation in mid-2020 of two popular disinfectants used to produce them (the LpH and Vesphene family of disinfectants from STERIS Life Sciences).
It is essential to monitor the availability of disinfectants used in pharmaceutical cleaning protocols and proactively identify and prequalify alternatives with similar or better performance to any products that may potentially become inaccessible.
In addition, it is important to perform disinfectant qualifications as soon as possible when a new manufacturing area is starting up to demonstrate that a validated cleaning regime has been implemented. Additional disinfectant prequalification testing can be performed if new microbes are detected or any questions raised by trending data arise.
Expertise is essential
Trending data obtained during the environmental monitoring of pharmaceutical manufacturing areas should be used to select relevant environmental isolates for use in growth promotion testing and disinfectant qualification to ensure that cleaning regimens are effective against the typical organisms found in those areas.
Doing so may involve extensive time, effort and resources, but this work is essential because it ensures the safety of drug and medical device products.
The consequences of not implementing an effective cleaning regimen can be very serious; in the best case, production batches are lost and time must be spent identifying the root cause of the contamination, resulting in costs to the manufacturer. At worst, patients placed at risk may become sick or even die.
The entire process, from environmental monitoring to cleaning regimen development and implementation, can be facilitated by collaborating with a team with extensive experience in the field.
The best partners can support all the activities related to ensuring continued compliance and patient safety. They know which tests to perform, how to interpret the results and the necessary actions that should be taken.
Cambrex is one of the few service providers that can support all aspects of microbiology, cleanroom services, environmental monitoring and disinfectant qualification, offering flexible services from comprehensive support to targeted solutions.
The company has more than 30 years of experience gained from working with many different pharmaceutical and medical device clients in a wide range of industries. As a result, we have developed a deep understanding of what is required, even for the most complicated projects.
References
- www.who.int/medicines/areas/quality_safety/quality_assurance/GMPSterilePharmaceuticalProductsTRS961Annex6.pdf.
- www.who.int/immunization_standards/vaccine_quality/env_monitoring_cleanrooms_final.pdf?ua=1.
- www.pda.org/bookstore/product-detail/4394-tr-70-cleaning-and-disinfection-programs.
- https://shop.bsigroup.com/ProductDetail?pid=000000000030379556.
- www.usp.org/harmonization-standards/pdg/general-methods/sterility-test.
- www.drugfuture.com/pharmacopoeia/usp35/PDF/0619-0622%20%5B1072%5D%20DISINFECTANTS%20AND%20ANTISEPTICS.pdf.
- www.pda.org/pda-europe/news-archive/full-story/2015/05/27/usp-1116-and-its-implications-for-measuring-microbial-recovery-rates.
- http://microbiologynetwork.com/usp-microbiological-best-laboratory-practices.asp.
- www.fda.gov/media/88801/download.
- www.fda.gov/inspections-compliance-enforcement-and-criminal-investigations/compliance-actions-and-activities/warning-letters.
- www.epa.gov/pesticide-reevaluation/registration-review-schedules.